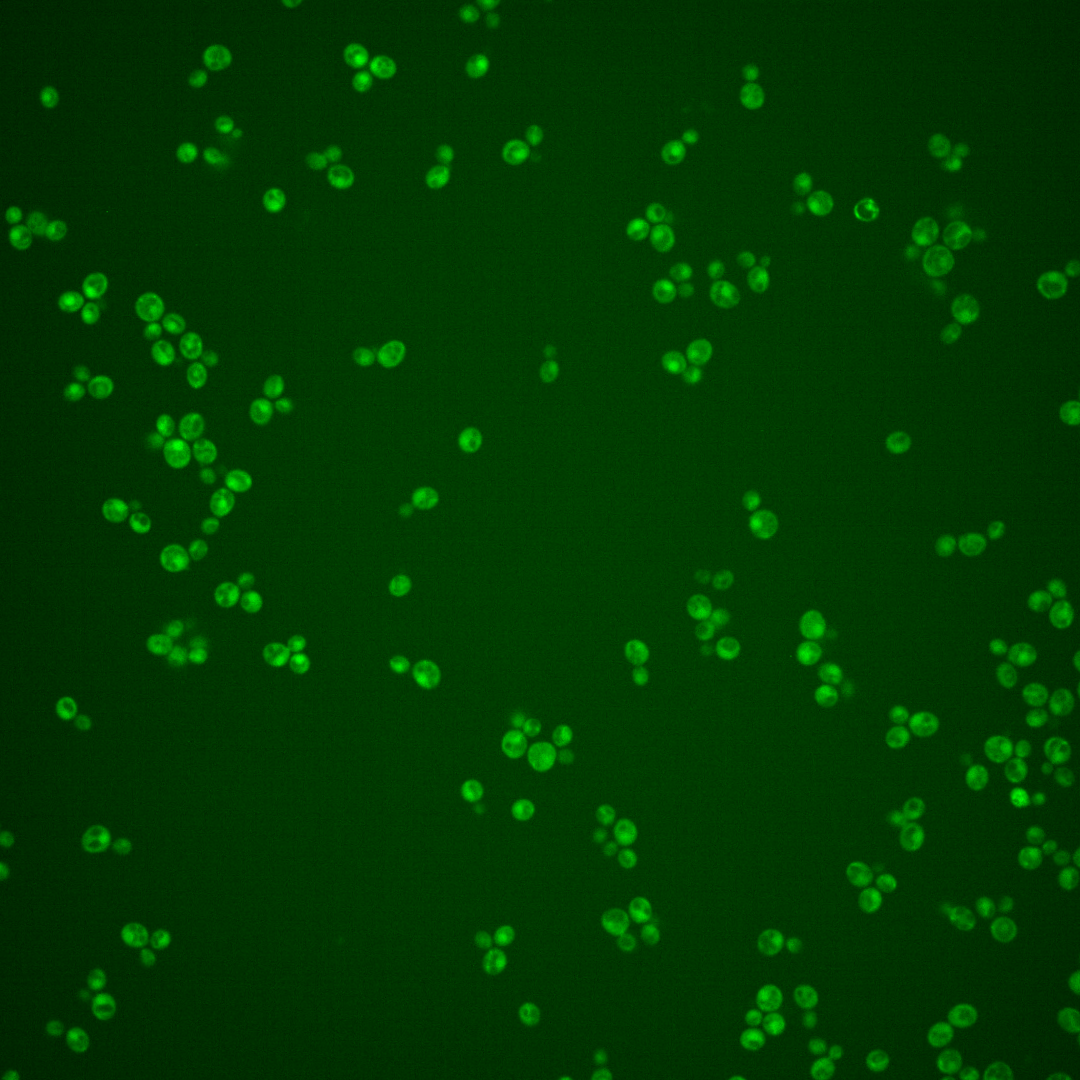
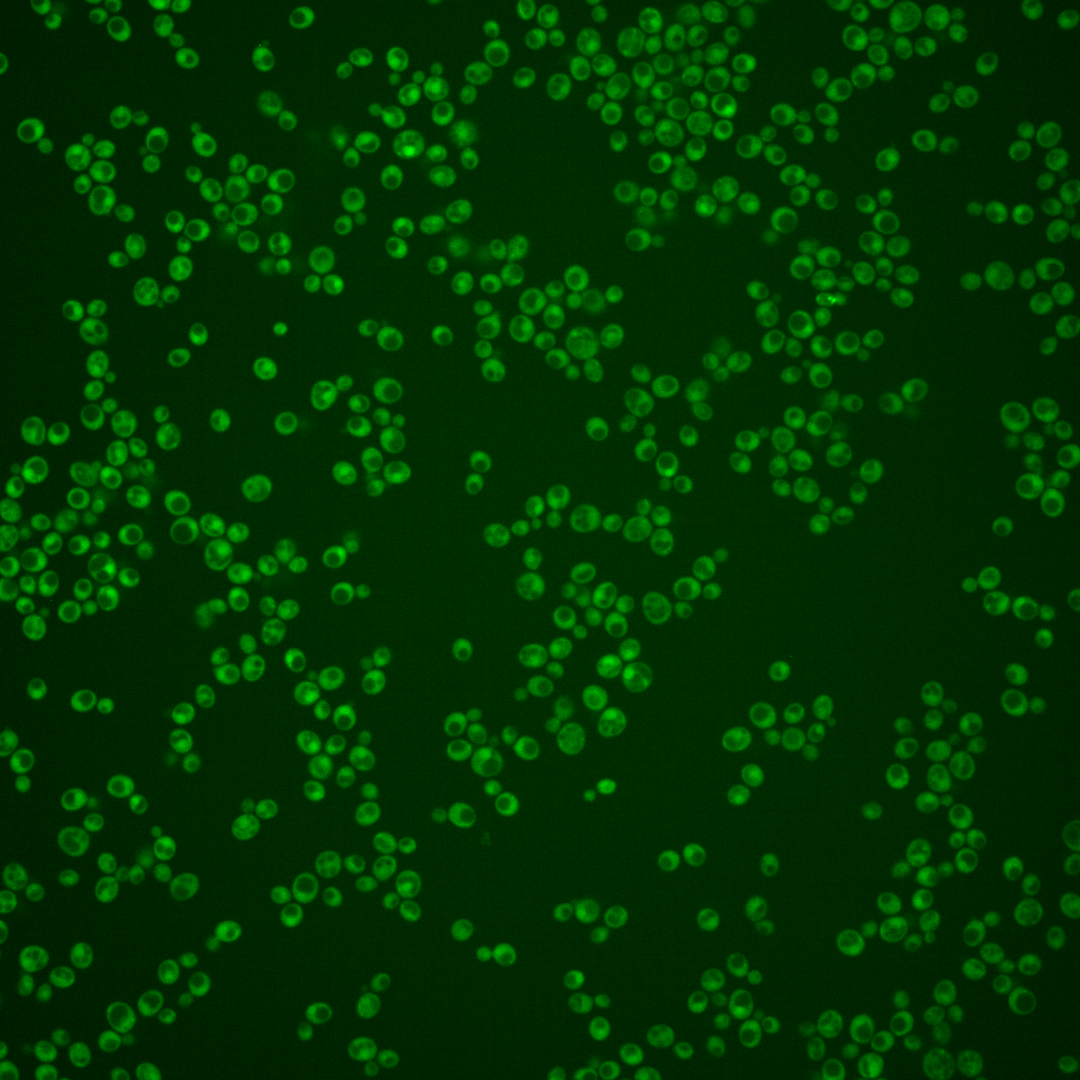
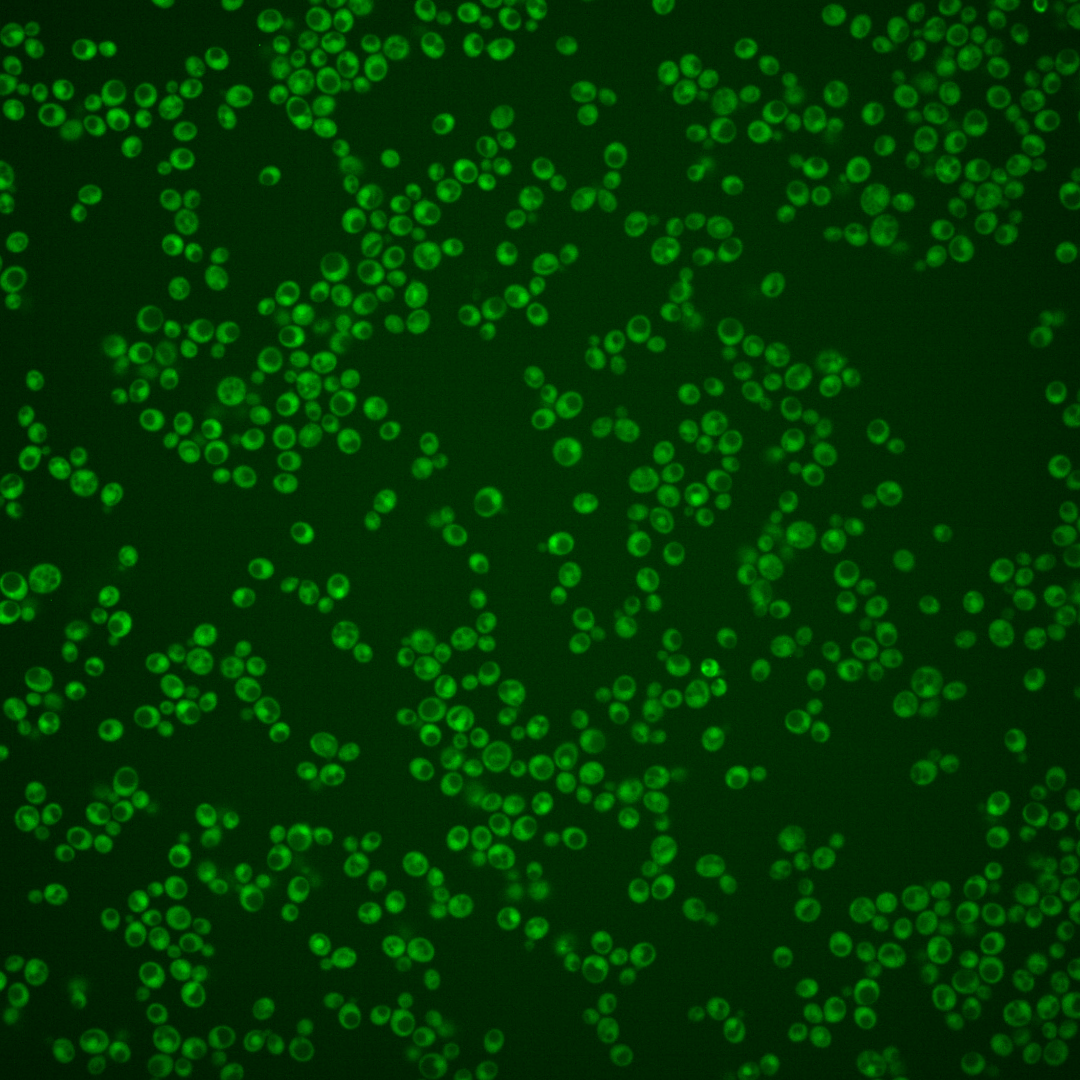
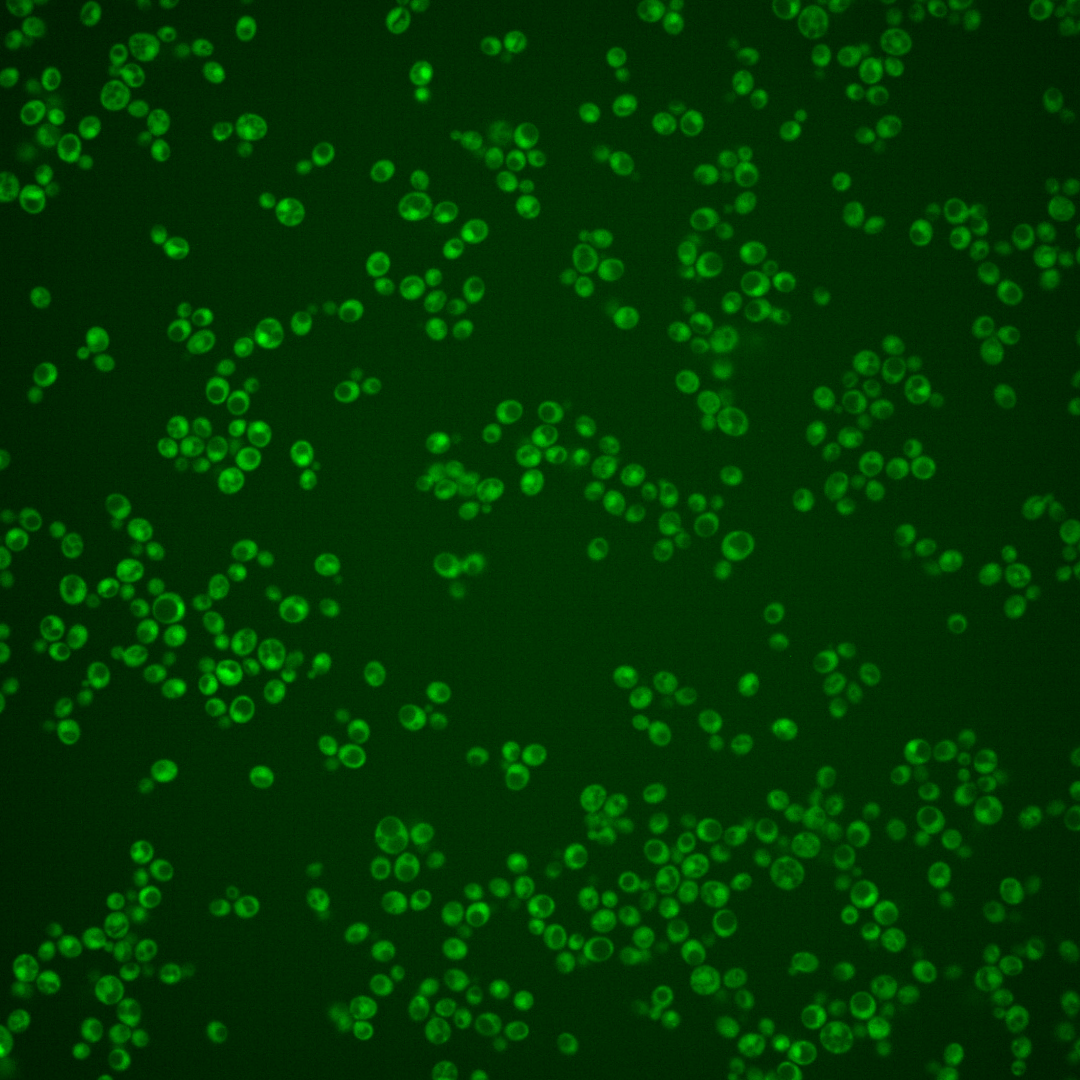

| ORF | |
|---|---|
| Human Ortholog | |
| Description | Protein of unknown function; green fluorescent protein (GFP)-fusion protein localizes to the cytoplasm in a punctate pattern; YDR222W has a paralog, YLR225C, that arose from the whole genome duplication |
Micrographs




















































































Sub-cellular Localization
Yeast GFP Assignment
Protein Abundance
Localization Change
External localization resources
| ensLOC | DeepLoc | |||||||||||||||||||||||
|---|---|---|---|---|---|---|---|---|---|---|---|---|---|---|---|---|---|---|---|---|---|---|---|---|
| Localization | WT1 | WT2 | WT3 | RAP60 | RAP140 | RAP220 | RAP300 | RAP380 | RAP460 | RAP540 | RAP620 | RAP700 | HU80 | HU120 | HU160 | rpd3Δ_1 | rpd3Δ_2 | rpd3Δ_3 | WT1 | WT2 | WT3 | AF100 | AF140 | AF180 |
| Cortical Patches | 0 | 0 | 0 | 0 | 0 | 0 | 0 | 0 | 0 | 0 | 0 | 0 | 0 | 0 | 0 | 0 | 0 | 0 | 9 | 5 | 9 | 2 | 2 | 2 |
| Bud | 1 | 1 | 0 | 0 | 3 | 1 | 6 | 6 | 6 | 11 | 4 | 11 | 0 | 0 | 0 | 0 | 0 | 0 | 0 | 2 | 7 | 4 | 3 | 7 |
| Bud Neck | 0 | 1 | 2 | 0 | 4 | 2 | 2 | 0 | 1 | 6 | 0 | 3 | 1 | 6 | 4 | 0 | 2 | 2 | 2 | 0 | 2 | 2 | 0 | 3 |
| Bud Site | 0 | 0 | 0 | 0 | 0 | 0 | 0 | 2 | 2 | 1 | 2 | 0 | 0 | 0 | 0 | 0 | 0 | 0 | – | – | – | – | – | – |
| Cell Periphery | 0 | 1 | 3 | 0 | 0 | 1 | 3 | 1 | 0 | 1 | 2 | 1 | 0 | 5 | 1 | 7 | 4 | 9 | 4 | 1 | 4 | 0 | 2 | 1 |
| Cytoplasm | 408 | 223 | 293 | 159 | 237 | 241 | 311 | 260 | 304 | 304 | 128 | 196 | 321 | 522 | 506 | 184 | 269 | 208 | 333 | 208 | 211 | 207 | 302 | 264 |
| Endoplasmic Reticulum | 2 | 3 | 2 | 0 | 1 | 2 | 0 | 0 | 0 | 1 | 1 | 1 | 1 | 2 | 1 | 6 | 14 | 14 | 2 | 1 | 5 | 0 | 0 | 2 |
| Endosome | 0 | 0 | 0 | 1 | 0 | 0 | 1 | 0 | 0 | 1 | 0 | 0 | 1 | 0 | 1 | 3 | 3 | 2 | 4 | 2 | 5 | 1 | 1 | 2 |
| Golgi | 0 | 0 | 2 | 0 | 0 | 0 | 0 | 0 | 0 | 0 | 0 | 0 | 0 | 0 | 0 | 3 | 1 | 0 | 2 | 0 | 3 | 1 | 0 | 0 |
| Mitochondria | 37 | 6 | 6 | 14 | 24 | 100 | 149 | 119 | 169 | 228 | 153 | 188 | 0 | 0 | 0 | 0 | 9 | 12 | 27 | 10 | 43 | 5 | 8 | 12 |
| Nucleus | 0 | 0 | 1 | 1 | 2 | 0 | 0 | 1 | 2 | 0 | 2 | 3 | 2 | 0 | 1 | 1 | 1 | 0 | 0 | 0 | 1 | 0 | 1 | 0 |
| Nuclear Periphery | 1 | 0 | 0 | 0 | 0 | 1 | 1 | 0 | 0 | 0 | 1 | 0 | 1 | 0 | 0 | 0 | 1 | 0 | 0 | 0 | 0 | 0 | 0 | 1 |
| Nucleolus | 0 | 0 | 1 | 0 | 0 | 0 | 1 | 3 | 0 | 0 | 0 | 1 | 0 | 0 | 0 | 0 | 1 | 0 | 0 | 0 | 0 | 0 | 0 | 0 |
| Peroxisomes | 0 | 0 | 0 | 1 | 0 | 0 | 0 | 0 | 1 | 0 | 0 | 1 | 0 | 0 | 0 | 0 | 0 | 0 | 0 | 0 | 0 | 0 | 0 | 0 |
| SpindlePole | 2 | 0 | 0 | 0 | 2 | 2 | 12 | 12 | 17 | 6 | 2 | 7 | 0 | 0 | 0 | 0 | 5 | 1 | 2 | 1 | 5 | 3 | 4 | 7 |
| Vac/Vac Membrane | 0 | 2 | 0 | 0 | 2 | 2 | 2 | 1 | 2 | 5 | 2 | 6 | 0 | 0 | 0 | 2 | 5 | 5 | 3 | 2 | 3 | 1 | 3 | 4 |
| Unique Cell Count | 427 | 230 | 302 | 160 | 256 | 291 | 396 | 334 | 413 | 437 | 238 | 327 | 323 | 524 | 508 | 191 | 285 | 222 | 406 | 238 | 315 | 238 | 339 | 320 |
| Labelled Cell Count | 451 | 237 | 310 | 176 | 275 | 352 | 488 | 405 | 504 | 564 | 297 | 418 | 327 | 535 | 514 | 206 | 315 | 253 | 406 | 238 | 315 | 238 | 339 | 320 |
Yeast GFP Assignment
Protein Abundance
| Screen | WT1 | WT2 | WT3 | RAP60 | RAP140 | RAP220 | RAP300 | RAP380 | RAP460 | RAP540 | RAP620 | RAP700 | HU80 | HU120 | HU160 | rpd3Δ_1 | rpd3Δ_2 | rpd3Δ_3 | AF100 | AF140 | AF180 |
|---|---|---|---|---|---|---|---|---|---|---|---|---|---|---|---|---|---|---|---|---|---|
| Mean Cell GFP Intensity (1e-4) | 3.2 | 3.9 | 3.8 | 3.6 | 3.3 | 2.8 | 2.9 | 2.8 | 2.8 | 2.6 | 2.4 | 2.5 | 5.5 | 5.1 | 5.0 | 5.7 | 4.9 | 5.0 | 5.7 | 5.5 | 5.9 |
| Std Deviation (1e-4) | 0.6 | 0.7 | 1.5 | 1.9 | 1.3 | 1.7 | 2.1 | 1.5 | 1.4 | 1.2 | 0.9 | 1.0 | 1.2 | 0.9 | 1.0 | 2.2 | 1.6 | 1.5 | 1.7 | 1.2 | 1.5 |
| Intensity Change (Log2) | – | – | – | -0.07 | -0.19 | -0.4 | -0.36 | -0.4 | -0.42 | -0.53 | -0.66 | -0.59 | 0.54 | 0.44 | 0.41 | 0.61 | 0.39 | 0.41 | 0.59 | 0.56 | 0.65 |
Localization Change
| Localization | RAP60 | RAP140 | RAP220 | RAP300 | RAP380 | RAP460 | RAP540 | RAP620 | RAP700 | HU80 | HU120 | HU160 | rpd3Δ_1 | rpd3Δ_2 | rpd3Δ_3 |
|---|---|---|---|---|---|---|---|---|---|---|---|---|---|---|---|
| Actin | – | – | – | – | – | – | – | – | – | – | – | – | – | – | – |
| Bud | – | – | – | – | – | – | – | – | – | – | – | – | – | – | – |
| Bud Neck | – | – | – | – | – | – | – | – | – | – | – | – | – | – | – |
| Bud Site | – | – | – | – | – | – | – | – | – | – | – | – | – | – | – |
| Cell Periphery | – | – | – | – | – | – | – | – | – | – | – | – | – | – | – |
| Cyto | – | – | – | – | – | – | – | – | – | – | – | – | – | – | – |
| Endoplasmic Reticulum | – | – | – | – | – | – | – | – | – | – | – | – | – | – | – |
| Endosome | – | – | – | – | – | – | – | – | – | – | – | – | – | – | – |
| Golgi | – | – | – | – | – | – | – | – | – | – | – | – | – | – | – |
| Mitochondria | – | – | – | – | – | – | – | – | – | – | – | – | – | – | – |
| Nuclear Periphery | – | – | – | – | – | – | – | – | – | – | – | – | – | – | – |
| Nuc | – | – | – | – | – | – | – | – | – | – | – | – | – | – | – |
| Nucleolus | – | – | – | – | – | – | – | – | – | – | – | – | – | – | – |
| Peroxisomes | – | – | – | – | – | – | – | – | – | – | – | – | – | – | – |
| SpindlePole | – | – | – | – | – | – | – | – | – | – | – | – | – | – | – |
| Vac | – | – | – | – | – | – | – | – | – | – | – | – | – | – | – |
| Cortical Patches | – | – | – | – | – | – | – | – | – | – | – | – | – | – | – |
| Cytoplasm | – | – | – | – | – | – | – | – | – | – | – | – | – | – | – |
| Nucleus | – | – | – | – | – | – | – | – | – | – | – | – | – | – | – |
| Vacuole | – | – | – | – | – | – | – | – | – | – | – | – | – | – | – |
External localization resources
Images






























Protein Concentration and Protein Localization Data
| R1 | R2 | R3 | ||||||||||||||||
|---|---|---|---|---|---|---|---|---|---|---|---|---|---|---|---|---|---|---|
| G1 Pre-START | G1 Post-START | S/G2 | Metaphase | Anaphase | Telophase | G1 Pre-START | G1 Post-START | S/G2 | Metaphase | Anaphase | Telophase | G1 Pre-START | G1 Post-START | S/G2 | Metaphase | Anaphase | Telophase | |
| Concentration | 1.098 | 1.6956 | 1.8165 | 1.6943 | 0.6772 | 1.4583 | 1.5988 | 0.5174 | 0.6598 | 0.6253 | 0.5499 | 0.273 | -0.3283 | -0.4118 | -0.0901 | 0.1474 | -0.102 | -0.3135 |
| Actin | 0.0184 | 0.0018 | 0.0103 | 0.0048 | 0.0013 | 0.0061 | 0.052 | 0.0078 | 0.0255 | 0.007 | 0.0186 | 0.0018 | 0.0566 | 0.0013 | 0.0029 | 0.0038 | 0.054 | 0.0021 |
| Bud | 0.0009 | 0.0006 | 0.0008 | 0.0013 | 0.0009 | 0.0007 | 0.0063 | 0.0037 | 0.0003 | 0.0008 | 0.0027 | 0.0002 | 0.0037 | 0.0007 | 0.0092 | 0.0031 | 0.0004 | 0.0002 |
| Bud Neck | 0.0012 | 0.0003 | 0.0015 | 0.0004 | 0.0006 | 0.0057 | 0.0025 | 0.0003 | 0.001 | 0.0275 | 0.0007 | 0.0004 | 0.0029 | 0.0001 | 0.0003 | 0.0006 | 0.0008 | 0.0005 |
| Bud Periphery | 0.0026 | 0.0014 | 0.001 | 0.0031 | 0.0014 | 0.0017 | 0.0143 | 0.0019 | 0.0003 | 0.0027 | 0.01 | 0.0005 | 0.0042 | 0.0016 | 0.004 | 0.0039 | 0.0007 | 0.0006 |
| Bud Site | 0.0031 | 0.002 | 0.0062 | 0.0007 | 0.0012 | 0.0004 | 0.01 | 0.011 | 0.0066 | 0.0079 | 0.0067 | 0.0001 | 0.0072 | 0.0009 | 0.0108 | 0.0055 | 0.0014 | 0.0002 |
| Cell Periphery | 0.0002 | 0.0002 | 0.0002 | 0.0002 | 0.0001 | 0.0001 | 0.0046 | 0.0004 | 0.0001 | 0.0003 | 0.0003 | 0 | 0.0005 | 0.0002 | 0.0004 | 0.0003 | 0.0002 | 0 |
| Cytoplasm | 0.081 | 0.1952 | 0.2071 | 0.2356 | 0.1898 | 0.1296 | 0.0942 | 0.1973 | 0.281 | 0.2629 | 0.1554 | 0.2418 | 0.104 | 0.1766 | 0.2557 | 0.0965 | 0.1849 | 0.237 |
| Cytoplasmic Foci | 0.0274 | 0.0055 | 0.0095 | 0.0067 | 0.0045 | 0.0131 | 0.0206 | 0.0062 | 0.0119 | 0.0129 | 0.0093 | 0.0174 | 0.0226 | 0.0034 | 0.0076 | 0.0105 | 0.0092 | 0.0054 |
| Eisosomes | 0.0004 | 0.0001 | 0.0002 | 0.0002 | 0.0001 | 0.0001 | 0.001 | 0.0001 | 0.0002 | 0.0002 | 0.0005 | 0.0001 | 0.0005 | 0.0001 | 0.0002 | 0.0002 | 0.0004 | 0.0001 |
| Endoplasmic Reticulum | 0.0033 | 0.0012 | 0.0023 | 0.0031 | 0.0011 | 0.0015 | 0.0167 | 0.0019 | 0.003 | 0.0022 | 0.0034 | 0.0023 | 0.003 | 0.0013 | 0.0025 | 0.0011 | 0.0038 | 0.0035 |
| Endosome | 0.0083 | 0.0021 | 0.0047 | 0.0029 | 0.0006 | 0.0032 | 0.0501 | 0.0012 | 0.006 | 0.0148 | 0.0201 | 0.006 | 0.0194 | 0.0006 | 0.0043 | 0.0009 | 0.0198 | 0.0113 |
| Golgi | 0.0028 | 0.0001 | 0.0016 | 0.0002 | 0.0001 | 0.0009 | 0.0189 | 0.0002 | 0.007 | 0.0072 | 0.0028 | 0.0011 | 0.008 | 0.0001 | 0.0019 | 0.0002 | 0.0033 | 0.0049 |
| Lipid Particles | 0.007 | 0.0001 | 0.0017 | 0.0003 | 0.0002 | 0.0004 | 0.0257 | 0.0004 | 0.0077 | 0.0175 | 0.0187 | 0.0009 | 0.0147 | 0.0002 | 0.004 | 0.0007 | 0.0039 | 0.0041 |
| Mitochondria | 0.0105 | 0.0003 | 0.0044 | 0.0007 | 0.0005 | 0.001 | 0.0189 | 0.0004 | 0.0022 | 0.0095 | 0.0115 | 0.001 | 0.0082 | 0.0003 | 0.008 | 0.0013 | 0.0011 | 0.0031 |
| None | 0.7913 | 0.7682 | 0.7227 | 0.7083 | 0.7822 | 0.8197 | 0.5476 | 0.7575 | 0.6278 | 0.5785 | 0.7083 | 0.716 | 0.7076 | 0.8101 | 0.6733 | 0.8528 | 0.7008 | 0.7087 |
| Nuclear Periphery | 0.0082 | 0.0047 | 0.002 | 0.0024 | 0.0016 | 0.0006 | 0.0331 | 0.0012 | 0.0012 | 0.0039 | 0.0091 | 0.0034 | 0.0112 | 0.0005 | 0.0021 | 0.0005 | 0.0066 | 0.006 |
| Nucleolus | 0.001 | 0.0005 | 0.0007 | 0.0003 | 0.001 | 0.0003 | 0.0015 | 0.0004 | 0.0002 | 0.0093 | 0.0007 | 0.0002 | 0.0007 | 0.0001 | 0.0006 | 0.0019 | 0.0002 | 0.0002 |
| Nucleus | 0.0048 | 0.008 | 0.0115 | 0.0245 | 0.0074 | 0.0015 | 0.0389 | 0.0027 | 0.0075 | 0.0085 | 0.008 | 0.0013 | 0.0017 | 0.0007 | 0.0059 | 0.0039 | 0.0016 | 0.0013 |
| Peroxisomes | 0.0199 | 0.002 | 0.0025 | 0.0007 | 0.0003 | 0.0062 | 0.0184 | 0.0002 | 0.0074 | 0.0127 | 0.0053 | 0.0005 | 0.0063 | 0.0001 | 0.0013 | 0.0047 | 0.0015 | 0.008 |
| Punctate Nuclear | 0.0052 | 0.0019 | 0.0077 | 0.002 | 0.0043 | 0.0069 | 0.0072 | 0.0033 | 0.0018 | 0.0086 | 0.0052 | 0.0035 | 0.0127 | 0.0005 | 0.0031 | 0.005 | 0.0036 | 0.0013 |
| Vacuole | 0.0015 | 0.0024 | 0.0013 | 0.0017 | 0.0006 | 0.0003 | 0.0141 | 0.0017 | 0.001 | 0.003 | 0.0018 | 0.0009 | 0.0023 | 0.0006 | 0.0014 | 0.0024 | 0.0013 | 0.0006 |
| Vacuole Periphery | 0.001 | 0.0012 | 0.0003 | 0.0001 | 0.0002 | 0.0001 | 0.0036 | 0.0002 | 0.0001 | 0.0021 | 0.0008 | 0.0004 | 0.0019 | 0.0001 | 0.0005 | 0.0002 | 0.0006 | 0.0009 |
Sequencing Data
| R1 | R2 | |||||||||
|---|---|---|---|---|---|---|---|---|---|---|
| G1 Post-START | S/G2 | Metaphase | Anaphase | Telophase | G1 Post-START | S/G2 | Metaphase | Anaphase | Telophase | |
| Gene Expression | 35.3655 | 21.3399 | 6.4513 | 7.0297 | 23.4996 | 22.9749 | 22.5756 | 12.1357 | 7.1794 | 22.9855 |
| Translational Efficiency | 1.5361 | 1.7664 | 0.7446 | 0.8338 | 1.5489 | 2.1914 | 1.2133 | 0.6834 | 1.2458 | 1.1425 |
Hit Data
| Dataset | Hit |
|---|---|
| Protein Concentration | ✘ |
| Protein Localization | ✘ |
| Gene Expression | ✔ |
| Translational Efficiency | ✘ |
Endocytosis
| Temp | Actin Patch (Sac6-tdTomato) | Cortical Patch (Sla1-GFP) | Late Endosome (Snf7-GFP) | Vacuole (Vph1-GFP) |
|---|---|---|---|---|
| 37℃ | ||||
| RT |
Cell Cycle Omics
CYCLoPs (Ydr222w-GFP)
| Gene / Allele | Actin Patch (Sac6-tdTomato) | Cortical Patch (Sla1-GFP) | Late Endosome (Snf7-GFP) | Vacuole (Sac6-tdTomato) |
|---|
| Gene | Images |
|---|
| Gene | Images |
|---|
Images are not yet available
Images are not yet available